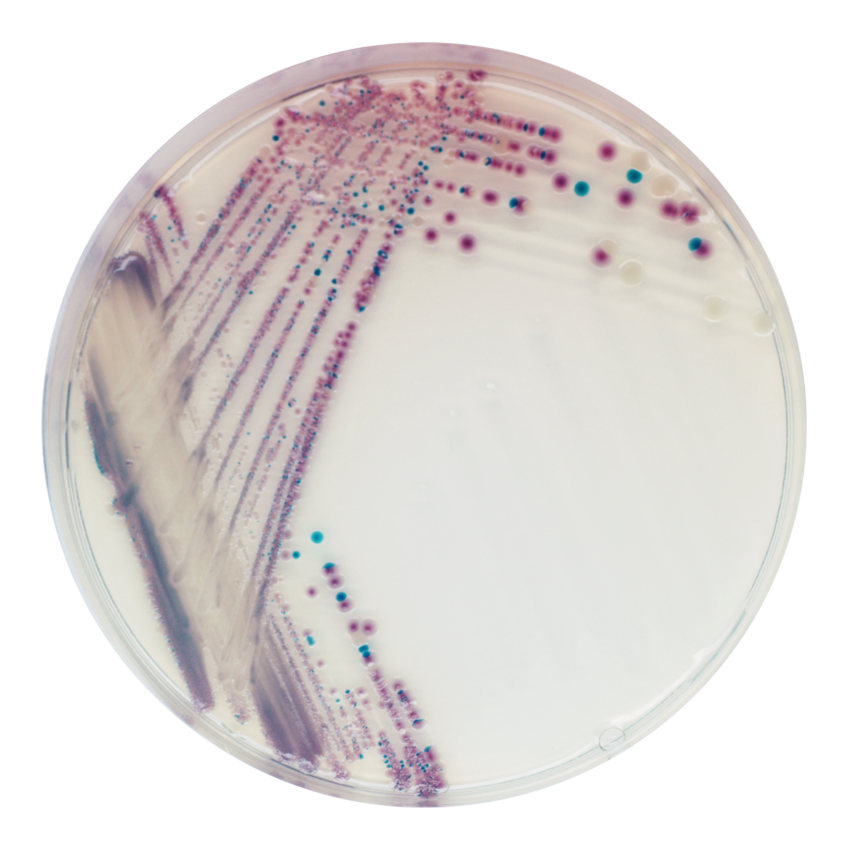

CHROMagar™ Vibrio
Để phân lập và phát hiện V. parahaemolyticus, V. vulnificus và V. cholerae
– VB912……..5000mL
– VB913…….. 25L

KHUẨN LẠC ĐIỂN HÌNH

V. parahaemolyticus
màu hoa cà

V. vulnificus / V. cholerae
Xanh lam đến xanh ngọc lam

V. alginolyticus
Kem
HIỆU NĂNG
Trong tự nhiên, Vibrio có mặt trên thực vật và động vật biển, chi Vibrio có hơn 20 loài, bốn trong số đó gây nguy hiểm nghiêm trọng cho sức khỏe cộng đồng.
V. cholerae thường gây bệnh tả do ô nhiễm nước và thực phẩm. Bệnh tả được coi là bệnh lưu hành theo chu kỳ ở nhiều quốc gia vì là một căn bệnh nguy hiểm gây tiêu chảy nặng và mất nước. Số ca bệnh tả được báo cáo cho WHO năm 2006 tăng lên đáng kể, đạt mức của những năm 1990. Khoảng 240.000 trường hợp được báo cáo ở 52 quốc gia, trong đó có khoảng 6.300 trường hợp tử vong.
V. parahaemolyticus và V. vulnificus có liên quan rộng rãi đến các bệnh do thực phẩm gây ra bởi hải sản, gây nhiễm trùng máu, nhiễm trùng vết thương và viêm ruột. CDC báo cáo ước tính số ca nhiễm Vibrio ở Hoa Kỳ tăng 47% (1996-1998 đến 2008), tương đương khoảng 8.000 ca bệnh mỗi năm. Nhiễm trùng Vibrio cũng thường xuyên được báo cáo ở các khu vực Châu Á và Châu Đại Dương do lượng tiêu thụ hải sản cao. Mặc dù V. parahaemolyticus là loài được báo cáo thường xuyên gây nhiễm trùng nhất, nhưng V. vunificus ngày càng phổ biến và hiện có liên quan đến 94% số ca tử vong được báo cáo.
V. alginolyticus ít phổ biến hơn nhưng lại là mầm bệnh đáng lo ngại cho người nuôi hàu vì nó có thể gây thiệt hại đáng kể về sản lượng. Nếu được phát hiện, nó có thể ngăn chặn sự lây nhiễm sang những con hàu khác.
1. Màu sắc khuẩn lạc rõ ràng và khác nhau: nhờ công nghệ tạo màu mạnh mẽ. Dễ đọc hơn đặc biệt so với môi trường TCBS truyền thống dựa trên quá trình lên men sucrose được thể hiện bằng chất chỉ thị pH.
2. Thuận tiện: V. alginolyticus không màu trong CHROMagar™ Vibrio, tránh gây nhiễu cho việc phát hiện các loài khác.
3. Phân biệt: giữa V. parahaemolyticus và V. vulnificus đều âm tính với sucrose (-) trên môi trường TCBS.
4. Hiệu quả mạnh mẽ : môi trường này có hiệu quả vượt trội và không thể so sánh với các môi trường nhuộm màu khác trong cùng lĩnh vực.
5. Năng suất vượt trội : cao hơn agar TCBS, ngay cả khi sử dụng môi trường tăng sinh. Ít âm tính giả hơn.
THÀNH PHẦN

TÀI LIỆU KỸ THUẬT
CÁC CÔNG BỐ KHOA HỌC